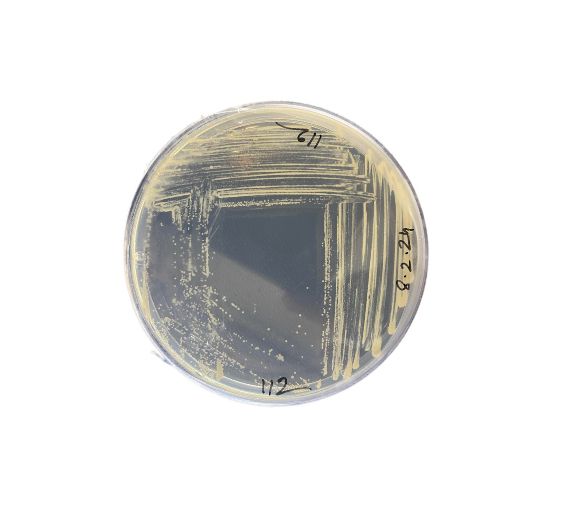

A University of Warwick, a Magyar Agrár- és Élettudományi Egyetem (MATE) és az Eötvös Loránd Tudományegyetem (ELTE) kutatóinak közös munkája során egy eddig ismeretlen baktériumfajt azonosítottak, amely képes a levegőben található szén-monoxid (CO) lebontására.
Az új faj a Foliimonas ilicis nevet kapta és az örökzöld magyal (Ilex aquifolium) leveleiről izolálták. Az eredményeket a kutatók az International Journal of Systematic and Evolutionary Microbiology című szaklapban tették közzé.
A felfedezés jelentősége abban áll, hogy a szén-monoxid-oxidáló baktériumokat eddig túlnyomórészt talajból ismerték. Városi környezetben azonban, ahol a szén-monoxid legnagyobb része keletkezik, a talajfelszínek döntő többsége burkolt. A lombfelületek viszont kiterjedt, levegővel érintkező élőhelyet biztosítanak, ezért a növények levelein élő mikroorganizmusok potenciálisan fontos szerepet tölthetnek be a városi levegő kémiai folyamataiban. A MATE Akvakultúra és Környezetbiztonsági Intézet kutatói, Dr. Táncsics András egyetemi tanár és Dr. Baka Erzsébet tudományos munkatárs véleménye szerint a Foliimonas ilicis felfedezése új megvilágításba helyezi a városi növényzet ökológiai szerepét. A filloszféra – vagyis a levelek felszínén élő mikrobiális közösség – vizsgálata hozzájárulhat annak megértéséhez, hogy a növényekkel együtt élő mikroorganizmusok milyen mértékben vesznek részt a légszennyező gázok természetes átalakításában.
A kutatók egyúttal hangsúlyozzák, hogy a városi zöldinfrastruktúra és a mikrobiális biodiverzitás kapcsolata kulcsszerepet játszhat a levegőminőség megőrzésében.
Forrás: Magyar Agrár- és Élettudományi Egyetem, továbbította a Helló Sajtó! Üzleti Sajtószolgálat.